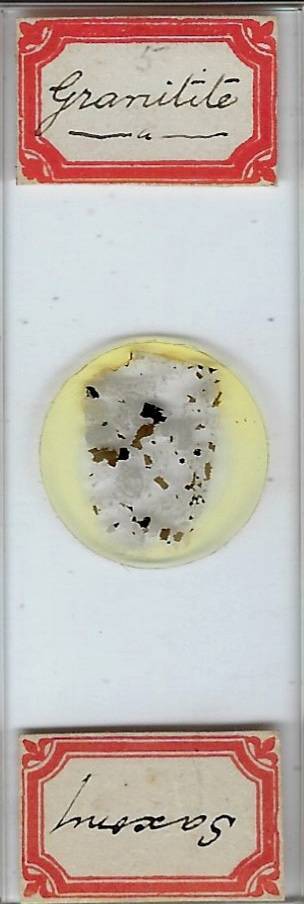
Granitite from Saxony Petrographic Microscope Slide

| Brand | Gakken |
|---|---|
| Model | Gakken no Kagaku |
| Type | Microscope & Specimen Kit |
| Country of Origin | Japan |
Check the listing for details. Gakken Science Microscope & Specimen Creation Kit - Genuine Experience Kit. Made in Japan. Listed at 62.06 USD. Series: Gakken no Kagaku.